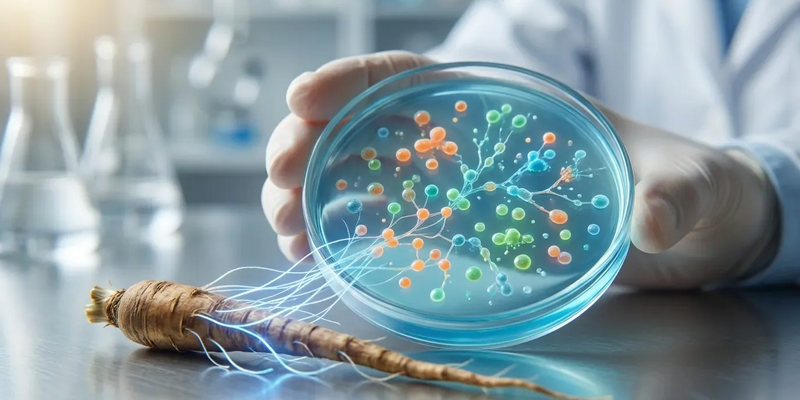
Wegwarte-Inulin hilft Darm nach Antibiotika-Therapie - Foto: über boerse-global.de

Wegwarte-Inulin hilft Darm nach Antibiotika-Therapie
23.01.2026 - 16:05:12Antibiotika bekämpfen Krankheitserreger, schädigen aber auch die nützlichen Bakterien im Darm. Diese Störung des mikrobiellen Gleichgewichts, eine Dysbiose, kann zu Verdauungsproblemen führen und wird mit langfristigen Gesundheitsrisiken in Verbindung gebracht. Jetzt rückt ein natürlicher Helfer in den Fokus: Inulin aus der Wegwarte-Wurzel.
Das Darm-Mikrobiom nach der Antibiotika-Kur
Breitband-Antibiotika reduzieren die Vielfalt der Darmbakterien drastisch. Die Erholung dieses komplexen Ökosystems kann Wochen oder Monate dauern. Manche nützlichen Bakterienstämme kehren nie in ihrer ursprünglichen Stärke zurück. Die Folge: Schädliche Keime finden leichter Platz, und die Produktion wichtiger Stoffe für die Darmschleimhaut bricht ein.
Wie Inulin die Darmflora füttert
Die Wurzel der Wegwarte (Zichorie) ist reich an dem Ballaststoff Inulin. Unverdaut erreicht er den Dickdarm und dient dort als präbiotische Nahrung. Er fördert gezielt das Wachstum gesundheitsfördernder Bakterien wie Bifidobakterien und Laktobazillen.
* Eine Meta-Analyse zeigt: Schon drei Gramm Zichorienwurzelfasern täglich lassen Bifidobakterien signifikant wachsen.
* Diese gezielte Unterstützung hilft, Lücken in der Darmflora nach Antibiotika schneller zu schließen.
Wenn Sie Ihre Darmgesundheit nach einer Antibiotika-Kur aktiv unterstützen wollen, hilft es, Laborwerte richtig zu deuten. Der kostenlose 25-seitige PDF-Report erklärt verständlich Erythrozyten, Hämoglobin, Leukozyten, Cholesterin, TSH und zehn wichtige Vitalstoff-Werte – inklusive Hinweise, welche Spezialtests sinnvoll sein können. Ideal für alle, die Befunde einordnen und gezielt handeln möchten. Kostenlosen Laborwerte-Report anfordern
Der wissenschaftliche Mechanismus dahinter
Die nützlichen Bakterien fermentieren das Inulin. Dabei entstehen kurzkettige Fettsäuren wie Butyrat. Diese Substanzen sind der Treibstoff für die Zellen der Darmschleimhaut. Sie stärken die Darmbarriere, wirken entzündungshemmend und erschweren das Wachstum schädlicher Keime. Eine präbiotische Kur kann so die Regenerationsphase nach einer Antibiotika-Behandlung verkürzen.
Präbiotika: Der neue Trend für die Darmgesundheit
Das Interesse verschiebt sich von reinen Probiotika (lebenden Bakterien) hin zu ganzheitlichen Ansätzen. Immer mehr Verbraucher suchen natürliche, evidenzbasierte Wege für ihr Wohlbefinden. Inulin aus der Zichorienwurzel ist pflanzlich und gut erforscht. Die Lebensmittelindustrie reagiert bereits und reichert Produkte wie Joghurts oder Müslis mit dem Ballaststoff an.
Zukunft: Personalisierte Darmsanierung?
Die Mikrobiom-Forschung schreitet schnell voran. Künftig könnten präbiotische Empfehlungen genau auf die individuelle Darmflora abgestimmt werden. Neue Studien untersuchen, wie ein breiteres Bakterienspektrum auf Inulin reagiert. Experten halten es für möglich, dass Ärzte künftig standardmäßig eine präbiotische Begleitung zur Antibiotika-Therapie empfehlen. Die unscheinbare Wegwarte würde dabei eine Schlüsselrolle spielen.